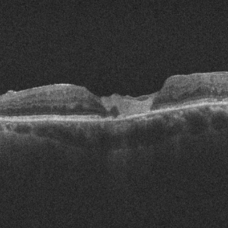

-
 Chronic Full Thickness Macular Hole
Chronic Full Thickness Macular Hole
Oct 25 2023 by Jessica Hampton, BS
Optical-coherence tomography image of a 65-year old woman with a chronic full-thickness macular hole in the left eye, recurred following three attempts at repair with pars plana vitrectomy, membrane peel, and gas tamponade.
Photographer: Dr. Diana Do, Stanford Medicine, Byers Eye Institute
Condition/keywords: full thickness macular hole, optical coherence tomography (OCT)
-
Amniotic-Membrane Grafted Macular Hole
Amniotic-Membrane Grafted Macular Hole
Oct 25 2023 by Jessica Hampton, BS
Optical-coherence tomography image of a 67-year old woman with a recurrent, chronic full-thickness macular hole in the left eye repaired with an amniotic membrane graft, seen at 2 years follow up.
Photographer: Dr. Diana Do, Stanford Medicine, Byers Eye Institute
Condition/keywords: amniotic membrane graft, full thickness macular hole
-
 Full Thickness Macular Hole
Full Thickness Macular Hole
Oct 25 2023 by Jessica Hampton, BS
Fundus photograph of a 67-year-old woman with a history of recurrent, chronic full-thickness macular hole in the left eye repaired with an amniotic membrane graft, seen at 2 years follow-up.
Photographer: Dr. Diana Do, Stanford Medicine, Byers Eye Institute
Condition/keywords: amniotic membrane graft, full thickness macular hole, fundus photograph

A project from the American Society of Retina Specialists